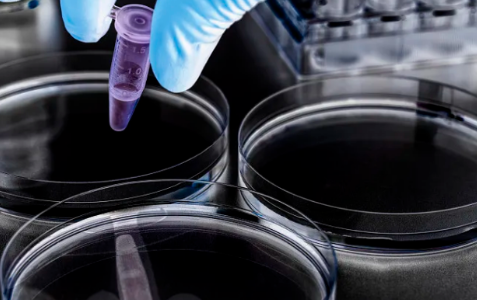
image.png

干細(xì)胞美膚的療愈過程,干細(xì)胞護(hù)膚真的好用嗎
2024-10-23 11:14:30 來源: 小編 咨詢醫(yī)生
干細(xì)胞美容是近年來迅速走紅的新興護(hù)膚療法,將科學(xué)與美容結(jié)合,旨在通過干細(xì)胞的再生與修復(fù)能力,改善皮膚狀態(tài),實(shí)現(xiàn)煥膚效果。那么,干細(xì)胞美膚到底是如何發(fā)揮作用的呢?
1.干細(xì)胞的基本概念
干細(xì)胞是具有自我更新和多向分化能力的細(xì)胞,能夠分化為多種特定細(xì)胞類型。在美容領(lǐng)域,最常用的干細(xì)胞主要分為兩種:胚胎干細(xì)胞和成人干細(xì)胞。成人干細(xì)胞主要來源于自身皮膚、脂肪組織及骨髓等,相對(duì)而言更為安全和有效。
2.干細(xì)胞美容的機(jī)制
干細(xì)胞美容主要通過以下幾個(gè)機(jī)制實(shí)現(xiàn)皮膚的改善:
促進(jìn)再生:干細(xì)胞能夠釋放生長(zhǎng)因子和細(xì)胞因子,這些物質(zhì)對(duì)于刺激皮膚細(xì)胞的增殖與重生至關(guān)重要。尤其是表皮細(xì)胞和真皮細(xì)胞,受到這些因子的影響后,能更快地進(jìn)行更新,達(dá)到光滑和緊致的效果。
抗老化:隨著年齡的增長(zhǎng),皮膚中的干細(xì)胞數(shù)量減少,導(dǎo)致皮膚失去彈性與光澤。干細(xì)胞美容可以補(bǔ)充這些流失的細(xì)胞,從而減緩老化過程,恢復(fù)皮膚的活力與青春。
修復(fù)效果:干細(xì)胞具有優(yōu)秀的修復(fù)能力,能夠?qū)弓h(huán)境污染、紫外線等因素造成的肌膚損傷。通過刺激膠原蛋白和彈力纖維的合成,干細(xì)胞美容能夠有效改善皮膚的松弛、皺紋等問題。
3.干細(xì)胞護(hù)膚產(chǎn)品的選擇
市場(chǎng)上已經(jīng)出現(xiàn)了多種干細(xì)胞護(hù)膚產(chǎn)品,主要包括以下幾類:
干細(xì)胞精華:富含植物干細(xì)胞或人源干細(xì)胞提取物,能夠激活肌膚再生,改善膚色不均和膚質(zhì)。
干細(xì)胞面膜:通常采用高濃度干細(xì)胞成分,能有效滲透肌膚,提供深層滋養(yǎng),適合需要修復(fù)和滋潤(rùn)的肌膚。
干細(xì)胞微針療法:通過微針將干細(xì)胞直接送入肌膚深層,能夠加速吸收并實(shí)現(xiàn)更顯著的效果,但需由專業(yè)人士操作。
4.治療過程與效果
干細(xì)胞美容療程一般分為以下幾個(gè)步驟:
1.評(píng)估:專業(yè)人士會(huì)根據(jù)顧客的膚質(zhì)、需求與問題進(jìn)行詳細(xì)評(píng)估。
2.清潔:對(duì)面部進(jìn)行深層清潔,以確保后續(xù)產(chǎn)品能更好滲透。
3.干細(xì)胞導(dǎo)入:根據(jù)選擇的美容方式(如面膜、精華或微針),將干細(xì)胞成分深層導(dǎo)入肌膚。
4.恢復(fù)與維護(hù):治療后需要一定的恢復(fù)時(shí)間,適當(dāng)使用后續(xù)護(hù)膚產(chǎn)品,保持效果。
臨床研究表明,經(jīng)過一段時(shí)間調(diào)理后,許多顧客確實(shí)能夠看到明顯的護(hù)膚效果,包括皮膚紋理的改善、色澤的均勻和緊致度的提升。
5.安全性與注意事項(xiàng)
雖然干細(xì)胞美容有很多潛在的好處,但顧客在選擇時(shí)仍需謹(jǐn)慎。應(yīng)選擇信譽(yù)良好的機(jī)構(gòu)和產(chǎn)品,確保使用的干細(xì)胞來源安全。同時(shí),每個(gè)人的膚質(zhì)不同,效果也會(huì)有所差異,治療前需與專業(yè)人士深入溝通,了解適合自己的方案。
總結(jié)
干細(xì)胞美膚技術(shù)的發(fā)展為現(xiàn)今護(hù)膚市場(chǎng)帶來了新的希望。雖然其效果因人而異,但越來越多的用戶正在見證其獨(dú)特的美容效果。如果你在尋找全新的護(hù)膚解決方案,干細(xì)胞美容或許值得一試。
-
下一頁(yè): 干細(xì)胞注射后美容效果附注意事項(xiàng)
- 2024-10-25干細(xì)胞治療不適宜人群有哪些?如何判斷自己是否適合干細(xì)胞療法?
- 2024-08-26造血干細(xì)胞捐獻(xiàn)條件和過程
- 2024-10-16造血干細(xì)胞干什么的,造血干細(xì)胞的特征和作用解析
- 2024-11-05腦癱干細(xì)胞移植是什么意思?移植治療的效果怎么樣?
- 2024-10-02嘉興人體干細(xì)胞有哪些作用,應(yīng)用前景如何
- 2024-11-02骨髓造血干細(xì)胞正常范圍值是多少?可以再生嗎?
- 2024-09-04干細(xì)胞抗衰老有效果嗎,有副作用嗎
- 2024-09-27廣州貝拉醫(yī)療門診部正規(guī)嗎
- 2024-08-12脂肪干細(xì)胞抗衰老有效果嗎
- 2024-09-07干細(xì)胞療法要做多久,打一次干細(xì)胞能維持多久
- 2024-10-04蘋果干細(xì)胞修復(fù)效果神奇?哪些產(chǎn)品才能真正生效?
- 2024-10-11干細(xì)胞抗衰老真的靠譜嗎?哪些人群適合做?
- 2024-08-26干細(xì)胞移植后皮膚排異怎么辦,會(huì)持續(xù)多久
- 2024-09-13山東莒縣捐贈(zèng)干細(xì)胞機(jī)構(gòu)有哪些,內(nèi)附名單表
- 2024-10-12山東干細(xì)胞治療中風(fēng)的費(fèi)用是多少?與常規(guī)治療相比如何?
- 2024-09-12醫(yī)院保存干細(xì)胞是干什么的,要多少錢
- 2024-10-05 干細(xì)胞多少毫升才算有效?怎樣選擇合適的治療量?
- 2024-09-03哪兒打干細(xì)胞效果好,干細(xì)胞機(jī)構(gòu)權(quán)威排名
